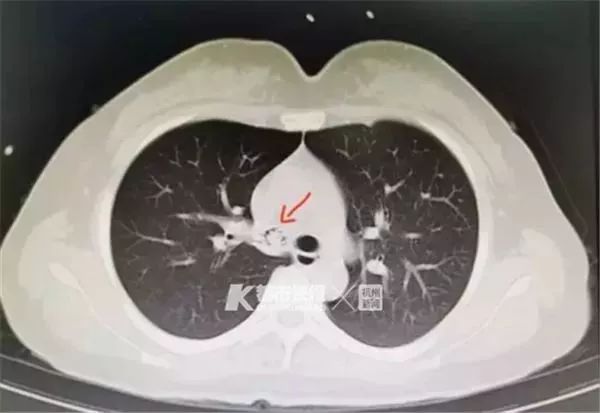
造成虾生病的原因,为什么虾会突然发病

“喂,今晚出黎宵夜啦! ”
夏日入夜后,约上三五知己
吹水喝啤,好不快活!

但是你知道吗
一边开心聊天,一边吃东西
就增加了发生意外的风险
近日37岁的于女士
就因为口中含着一只虾时与家人说话
误将这只虾连壳带肉吸进了气管!
最后怎么样了?一起来了解一下!
吃虾从不靠手剥
这回却误入“气”途
于女士介绍,她家住三墩,和老公每周末都回去郊区钓鱼钓虾。
那天晚上,她们一家煮了一大盆白天钓来的虾,“我平常就特别爱吃虾,吃虾的经验也很丰富,速度也很快,都不用手剥,直接放嘴里‘去壳’的。”于女士回忆,当晚正在吃虾时,老公问了她一件事,于女士一扭头打算回答时,口中的虾子便“滑入”了气道。
也就是从这个时候开始,于女士感觉非常不适,“胸闷,咳嗽,大口地喘气,呼吸很困难”,本想试试休息一下,看看能否好转,可谁知“一躺下去就头晕目眩”。
意识到情况不对的她,在老公的陪同下赶往浙江医院三墩院区急诊科就诊。CT检查结果显示,在于女士的右肺中间支气管下端,卡着一个弯曲状的异物,结合于女士的自述,浙江医院呼吸内科杜坚宗副主任医师基本断定“就是那只误吸入肺部的虾”。
考虑到异物在肺部时间待得越久就越容易造成其他并发症,甚至对患者生命造成危害,杜坚宗立即为于女士“当场捉虾”,通过支气管镜下取异物术,准确找到了异物所在,并成功取出。

“根据取出后异物的大小判断,如果这只虾再在患者肺里待些时间,很可能会导致患者肺不张、肺脓肿,甚至带来更危险的后果。”杜坚宗说。
得到及时妥善治疗后的于女士,在办理出院手续时,对治愈她的医护人员再三道谢,同时表示想到误吸异物的情形都有些后怕。

一周收治多例气管异物患者
医生:夏季饮食注意别“激动”
无独有偶,一周后,三墩院区又接到一名把虾“吞”入气管的患者。64岁的陈先生退休后每周都和老同学吃饭聚会,进入夏季,啤酒配虾,堪称人间美味。
当晚,作为老班长的陈先生趁着酒劲一边吃虾一边给一桌同学讲起了各种笑话和段子,在整桌人放肆大笑声中,陈先生突然顿住,捂着自己的喉咙……

随后,陈先生被送至三墩院区急诊,CT显示左主支气管内见一“虾”状异物影,长约3.9cm。后经支气管镜下取异物术,陈先生吞进去的虾顺利被取出。
同一天,30岁的张先生因为误吞鸭软骨至气管,也做了同样的处理。走出医院的那一刻,他们依旧惊魂未定。

你以为只是个例?
nonono……
还有虾钳、整只小龙虾误入气管的案例。
你想想,
前一秒哈哈哈,
后一面卡龙虾,
真是太危险了!

医生杜坚宗介绍,气管异物非常危险,平时进食的时候,讲话、大笑,甚至进食太快,都有可能造成异物卡喉或者进入气道,尤其是会咽松弛的老人和咽喉发育不全的小孩。
“每年我们都会接诊多例因上述不当进食行为,造成的气管异物,取出诸如鸡骨头、尖椒头、假牙等异物。”杜坚宗提醒,一旦出现异物吸入,请立即停止进食,并尽快到医院就医,以免出现窒息等危险。
学会这些办法,远离异物卡喉
▼

一些人会用吞饭、喝醋、用手指掏等“土办法”,但其实这些办法不仅不能把异物除掉,反而会使异物在食管的位置更深入,带来以下风险:
-
若异物比较尖锐或比较大,可能会划伤食道。
-
有些人会进行催吐,可能导致窒息的风险。
-
还有些人觉得异物可以自己出来,不去管它,最后导致严重的并发症。
专家提醒,就餐时喉咙突然被东西卡住不要惊慌,应立即停止进食并判断食管中是否存在异物——如果吞入后没什么反应,一般情况下已经到胃里了,不用太担心。
如果出现吞咽困难、哽咽感、疼痛感、流口水等,那异物很可能卡到了食道。

这时一定要立马去医院将异物及时取出,否则异物滞留时间过长会 引起局部组织水肿或感染,还会导致多种并发症,如呼吸困难、食管穿孔、气管食管瘘、食管壁糜烂或血管破裂造成大出血等严重后果,甚至危及生命。
专家强调,如果平时吃东西感觉有异物卡喉,切记不可强行大量吞饭、喝水等,无论何时都一定要尽快到医院就诊,通过专业的手段取出异物,以免造成更严重的后果。

遇见老人或小孩有异物卡在了喉咙,
情况危急,
第一反应是帮他拍背?
这!是!错!的!

学学海姆立克急救法
正确的处理方式是使用海姆立克急救法,即“利用肺部残留气体,形成气流冲出异物”的急救办法。
壹
对较小的、无法站立的小孩,首先把孩子抱起来,一只手托住孩子下颌,手臂贴着孩子的前胸,另一只手托住孩子后颈部,让其脸朝下,在孩子背部中心拍1-5次,观察孩子是否将异物吐出。

如果上述操作异物没出来,可以采取另外一个姿势。把孩子翻过来,躺在坚硬的地面或床板上,抢救者跪下或立于其足侧,或取坐位,并使患儿骑在抢救者的大腿上,面朝前。
抢救者以两手的中指或食指,放在患儿胸廓下和脐上的腹部,快速向上重击压迫,但要很轻柔。重复,直至异物排出。
贰
对于能够站立的孩子或成人,从背后抱住孩子腹部,双臂围环其腰腹部,一手握拳,拳心向内按压于患者的肚脐和肋骨之间的部位;另一手捂按在拳头之上,双手急速用力向里向上挤压,反复实施,直至阻塞物吐出。

看完以后你是不是为
以前吃饭聊天哈哈哈的行为捏了一把汗呢?
这个坏习惯一定要改正
吃饭讲话激动
食物容易误入“歧途”
注意吞咽,别乐极生悲了!
好了,最后珠珠问一句

:


来源 | 广东卫生信息、都市快报、新华社、网络
编辑 | 大颖

广东电视珠江频道
微信公众号
GDTVZJPD2013
微博@珠江频道
给珠珠加鸡腿, 点个在看!